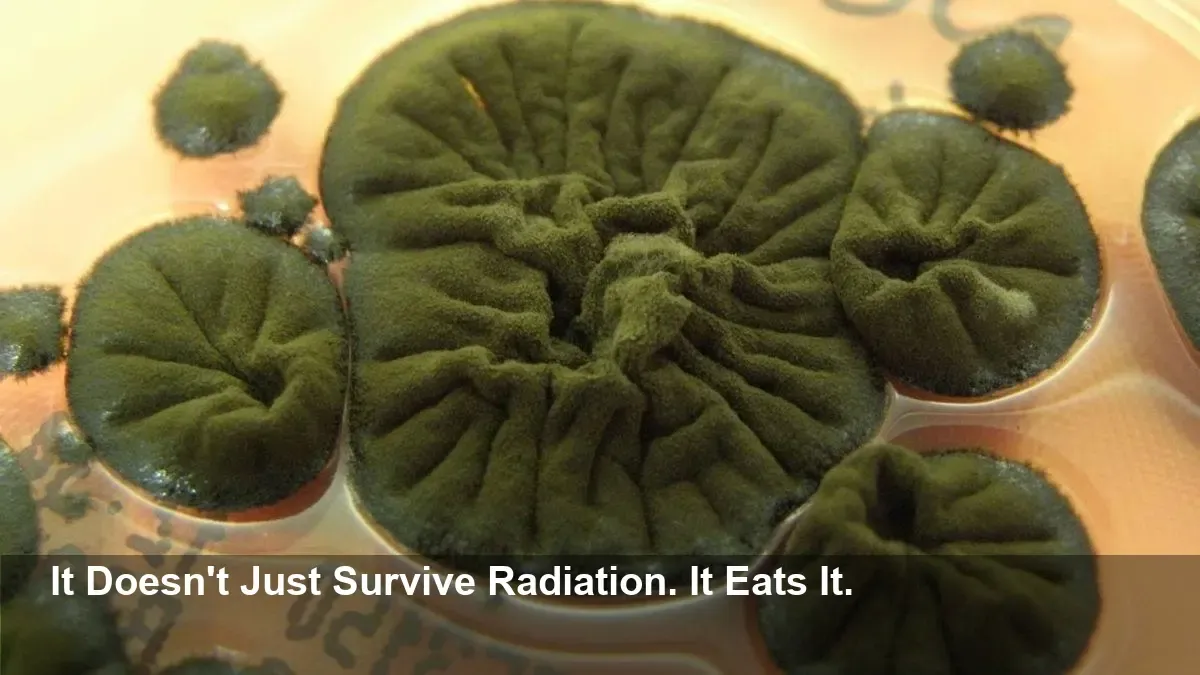
The Deadly Chernobyl Fungus's Secret is Out, and Scientists Are Stunned.

Chernobyl's Deadly Fungus Stuns Scientists
- A dark fungus, Cladosporium sphaerospermum, is thriving inside the highly radioactive ruins of the Chernobyl nuclear reactor.
- Scientists theorize the fungus uses its dark pigment, melanin, to convert deadly radiation into energy through a process called "radiosynthesis."
- This remarkable organism not only resists radiation but appears to grow better in its presence, a phenomenon that remains a profound scientific mystery.
- The fungus's shielding abilities are so promising that it was tested aboard the International Space Station as a potential radiation shield for astronauts.
Life Finds a Way in a Deadly Zone
In the shadow of the world's most infamous nuclear disaster, life persists in shocking ways. Nearly four decades after the Chernobyl reactor explosion, the exclusion zone has become a strange haven for wildlife. But deep within the reactor's contaminated walls, scientists have discovered something even more remarkable: a black fungus that doesn't just survive the intense radiation—it seems to feast on it.
This organism, Cladosporium sphaerospermum, was first identified in the late 1990s, clinging to the walls of the ruined Unit Four reactor. Its most notable feature is its dark hue, a result of high concentrations of melanin—the same pigment that colors human skin. This discovery sparked a fascinating and unsettling question: could this fungus be using melanin to harness radiation for energy?
The Radiosynthesis Hypothesis
Scientists proposed a groundbreaking theory known as "radiosynthesis." The idea is that the fungus might be using ionizing radiation in a manner similar to how plants use sunlight for photosynthesis. In this model, melanin acts like chlorophyll, absorbing harmful radiation and converting it into chemical energy, allowing the fungus to grow and thrive in an environment that would kill most other life forms.
Experiments have confirmed that C. sphaerospermum is not only strangely resistant to radiation but actually grows faster when exposed to it. While ionizing radiation shreds the DNA of most organisms, it appears to fuel this fungus's growth, an observation that has baffled researchers.
From Nuclear Ruin to Outer Space
The implications of this discovery are not just confined to Earth. The fungus's extraordinary ability to absorb radiation caught the attention of space exploration researchers. In a 2022 experiment, samples of C. sphaerospermum were sent to the International Space Station (ISS) and exposed to the harsh cosmic radiation of outer space. The results showed that the fungus could significantly reduce radiation levels, suggesting it could one day be used to create living, self-healing radiation shields for astronauts on long-duration missions to Mars and beyond.
An Unsolved Scientific Mystery
Despite these incredible findings, the theory of radiosynthesis remains unproven. Scientists have not yet been able to demonstrate a clear metabolic pathway or prove that the fungus is fixing carbon using radiation as an energy source. The central question persists: is this a unique evolutionary adaptation to "eat" radiation, or is it an incredibly robust stress response that allows the fungus to survive under the most extreme conditions? For now, this humble black fungus remains a symbol of nature's resilience, proving that life, indeed, finds a way.





